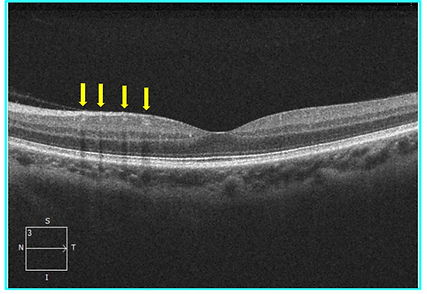
Retina 39-2.png

top of page
Patient Presentation: A 23-year-old obese female was diagnosed with idiopathic intracranial hypertension (IIH) and referred to neurosurgery for ventriculoperitoneal shunt. A baseline ocular examination was performed prior to the procedure.
On examination, vision was 20/200 in the right eye, and 20/40 in the left eye. There was a right relative afferent pupillary defect. Slit lamp examination was normal.
A dilated fundus examination was performed demonstrating the following:
Retina
Case 39
Patient Presentation: A 32-year-old male presents to the ophthalmology clinic for a routine follow-up assessment. His vision is 20/20 OD and 20/20 OS. His fundus examination was normal. The patient’s OCT macula is shown below.

Question: Which layer of the retina are the structures pointed by the yellow arrow located within?
bottom of page
.png)